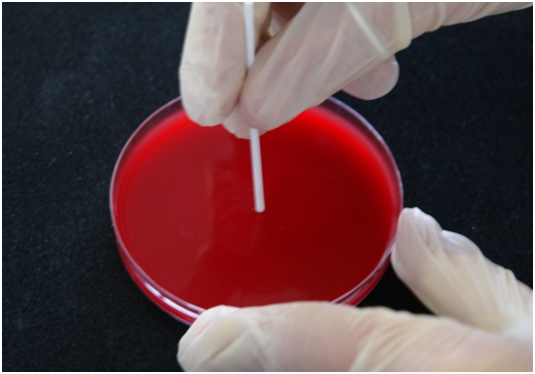

Presentazione
L'analisi identificativa degli isolati batterici mediante l'uso di tecniche fenotipiche convenzionali come le gallerie biochimiche, ampiamente in uso presso i comuni laboratori di microbiologia diagnostica, risulta spesso inadeguata per gli studi di tipo patogenetico molecolare ed epidemiologico, in cui è richiesta una sicura identificazione del batterio non solo a livello di specie, ma spesso di subspecie e di clone.
Risulta pertanto di importanza fondamentale, per la tipologia degli studi effettuati nel Laboratorio Patologia delle infezioni associate all'impianto, avvalersi di tecniche maggiormente affidabili e basate sulla tipizzazione genotipica degli isolati. A questo riguardo, la ribotipizzazione rappresenta una metodica recente e molto accreditata di tipizzazione genotipica, basata sull'analisi dei polimorfismi dei frammenti di restrizione dei geni codificanti gli RNA ribosomiali (rRNA 23S, 16S e 5S).

Il RiboPrinter® Microbial Characterization System (DuPont-Qualicon) del Laboratorio di Patologia delle infezioni associate all'impianto consente di effettuare la tipizzazione genotipica degli isolati mediante un processo di ribotipizzazione automatizzata, altrimenti noto come 'riboprinting'. Si tratta di un'ulteriore evoluzione rispetto alle metodiche di ribotipizzazione manuale, da tempo note e caratterizzate da un'elevata laboriosità e, talora, da una limitata riproducibilità.
In pratica, il RiboPrinter®, richiedendo solo un minimo intervento iniziale da parte dell'operatore, effettua automaticamente tutte le seguenti operazioni: lisi batterica, estrazione del DNA, digestione mediante enzimi di restrizione, separazione elettroforetica dei frammenti di restrizione, trasferimento degli stessi su membrana, ibridazione con sonda di DNA funzionalizzata con anticorpo in grado di emettere chemiluminescenza, digitalizzazione del segnale chemiluminescente, elaborazione dell'immagine in un profilo di ribotipizzazione, confronto con l'archivio DuPont di riboprofili, identificazione tassonomica dell'isolato e calcolo dell'indice di similarità rispetto ai ceppi di riferimento presenti nel database DuPont, attribuzione a specifici Ribogruppi in base alla similarità dei campioni precedentemente analizzati presso il Laboratorio.
Il portacampioni comprende 8 differenti postazioni nelle quali inserire 8 differenti isolati, che saranno processati contemporaneamente. Tutti gli isolati di un unico portacampioni vengono considerati come appartenenti ad uno stesso lotto o batch di analisi.

